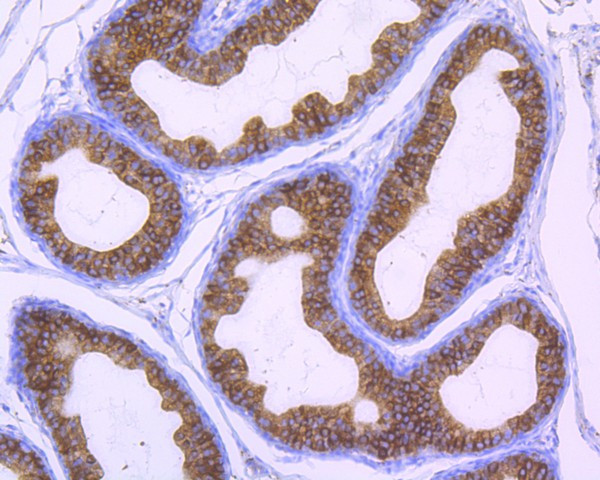
Cyclophilin B Antibody in Immunohistochemistry (Paraffin) (IHC (P))

Search
Invitrogen
Cyclophilin B Recombinant Rabbit Monoclonal Antibody (ST05-22)
{{$productOrderCtrl.translations['antibody.pdp.commerceCard.promotion.promotions']}}
{{$productOrderCtrl.translations['antibody.pdp.commerceCard.promotion.viewpromo']}}
{{$productOrderCtrl.translations['antibody.pdp.commerceCard.promotion.promocode']}}: {{promo.promoCode}} {{promo.promoTitle}} {{promo.promoDescription}}. {{$productOrderCtrl.translations['antibody.pdp.commerceCard.promotion.learnmore']}}
图: 1 / 4
Cyclophilin B Antibody (MA5-32170) in IHC (P)




产品信息
MA5-32170
宿主/亚型
Expression System
分类
类型
克隆号
抗原
偶联物
形式
浓度
规格
保存条件
运输条件
RRID
产品详细信息
Recombinant rabbit monoclonal antibodies are produced using in vitro expression systems. The expression systems are developed by cloning in the specific antibody DNA sequences from immunoreactive rabbits. Then, individual clones are screened to select the best candidates for production. The advantages of using recombinant rabbit monoclonal antibodies include: better specificity and sensitivity, lot-to-lot consistency, animal origin-free formulations, and broader immunoreactivity to diverse targets due to larger rabbit immune repertoire.
靶标信息
Immunophilins are a family of soluble cytosolic receptors capable of binding to one of two major immunosuppressant agents - cyclosporin A (CsA) or FK506. Proteins which bind FK506 are termed FK506 Binding Proteins (FKBP's) and those which bind cyclosporin A are called cyclophilins (CyP). Both CyP:CsA and FKBP:FK506 complexes have been shown to inhibit calcineurin, a calcium and calmodulin dependent protein phosphatase which has been implicated as an important signaling enzyme in T-cell activation. Thus, providing a possible mechanism of immunosuppression by CsA and FK506. Immunophilins function as peptidyl prolyl cis-trans-isomerases (PPIase) whose activity is inhibited by their respective immunosuppressant compounds. As PPIase's, immunophilins accelerate folding of some proteins both in vivo and in vitro by catalyzing slow steps in the initial folding and rearrangement of proline containing proteins.
仅用于科研。不用于诊断过程。未经明确授权不得转售。